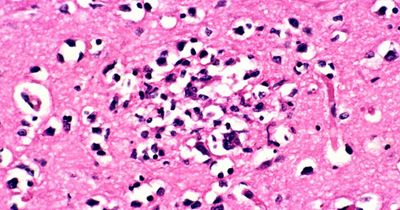
Common symptoms of Typhoid as cases of 'highly contagious' illness detected in Ireland

Get all your news in one place.
100’s of premium titles.
One app.
Start reading
One app.
Get all your news in one place.
100’s of premium titles. One news app.
The Latest Breaking News from Ireland
From analysis to the latest developments in health,
read the most diverse news in one place.
read the most diverse news in one place.


Read news from The Economist, FT, and more,
with one subscription
with one subscription
Get all your
news in one place.
news in one place.
100’s of premium titles.
One news app.
One news app.
Get all your
news in one place.
news in one place.
100’s of premium titles.
One news app.
One news app.
People
Tyson Fury
4,622 stories
Roy Keane
2,691 stories
Johnny Sexton
894 stories
Stephen Kenny
634 stories
Daniel Kinahan
411 stories
Michael D Higgins
304 stories
Leo Cullen
282 stories
Troy Parrott
278 stories
Mack Hansen
273 stories
James Lowe
268 stories
Bundee Aki
207 stories
Garry Ringrose
207 stories
Hugo Keenan
201 stories
Jamison GibsonPark
180 stories
Andrew Porter
165 stories
Robbie Henshaw
140 stories
Bridget
121 stories
Lenny
120 stories
Ross Byrne
98 stories
Finlay Bealham
92 stories
From analysis to the latest developments in health,
read the most diverse news in one place.
read the most diverse news in one place.

Organisations

Read news from The Economist, FT, and more,
with one subscription
with one subscription
Places
United States
346,575 stories
United Kingdom
132,825 stories
Russia
79,311 stories
England
67,406 stories
Europe
34,094 stories
Los Angeles
27,242 stories
Ireland
18,401 stories
Dublin
12,204 stories
Belfast
5,520 stories
Nigeria
3,980 stories
Omagh
399 stories
Co Antrim
234 stories
Sligo
209 stories
Cabra
16 stories